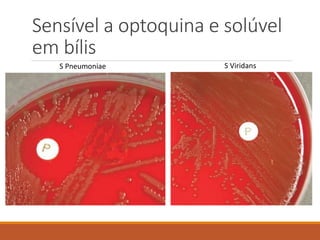
Sensível a optoquina e solúvel
em bílis
S Pneumoniae S Viridans

O documento descreve Streptococcus pneumoniae, a bactéria causadora da pneumonia e outras doenças invasivas. Ele discute a microbiologia, epidemiologia, diagnóstico e tratamento da doença pneumocócica, bem como o impacto da vacina pneumocócica conjugada de 13 valências na meningite pneumocócica em crianças nos EUA.